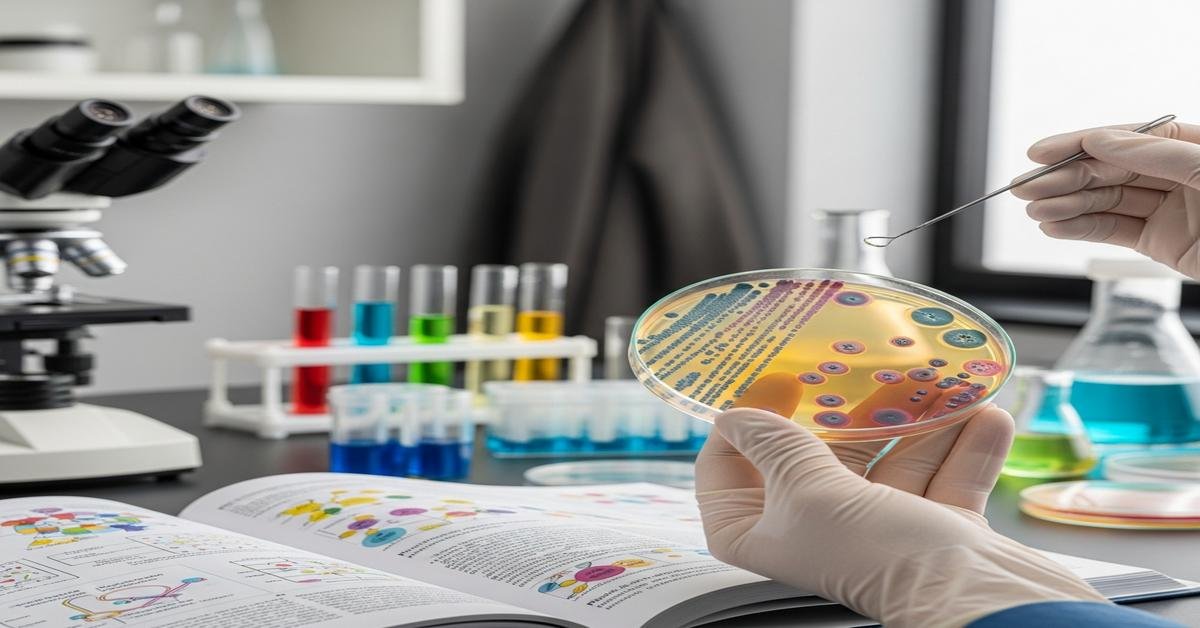
SMB (ASCP) Microbiology: The Specialist License, How to Master Clinical Microbiology for the ASCP Board

The ASCP Specialist in Microbiology is where clinical bench skill meets advanced judgment. It’s for people who can look at a plate, a Gram stain, or a PCR readout and think three steps ahead: “Is this real? Is it significant? What should I report—and why?” This guide explains what the credential is, how the exam works, and how to master the content with a practical, exam-focused plan that mirrors what you do in the lab.
What “SMB (ASCP)” Actually Means
The official ASCP Board of Certification credential is SM(ASCP) or SM(ASCP)CM (the “CM” indicates you maintain certification). You may see people write “SMB(ASCP)” or “SMB (ASCP)” informally to mean “Specialist in Microbiology,” but ASCP lists it as SM. That matters when you apply, update your resume, or verify credentials.
Eligibility, Application, and Exam Mechanics
Typical eligibility routes (verify current routes on the ASCP site before you apply):
- Bachelor’s degree in biological science or medical laboratory science plus about three years full-time clinical microbiology experience in a CLIA high-complexity lab.
- Master’s degree in a biological science plus about one year clinical micro experience.
- MLS(ASCP) certification plus additional experience in microbiology (often shorter than the bachelor’s-only route).
Why ASCP requires experience: the exam tests decisions you only make on the bench—rejecting poor specimens, interpreting mixed cultures, troubleshooting AST, and knowing when a “rare” organism is the real pathogen.
Application: create an ASCP account, submit transcripts, employment verification (with duties/time), and pay the specialist-level exam fee (budget a few hundred dollars). Processing may take several weeks.
Testing: offered year-round at Pearson VUE. Plan for about 2–2.5 hours of testing with optional breaks. Questions are computer-delivered multiple choice, often scenario-based.
Scoring: ASCP uses a scaled score (commonly 0–999 with 400 as the passing standard). You’ll usually see an unofficial result at the test center.
What the Exam Covers (High-Yield Map)
Weights vary slightly, but you can expect something like:
- Bacteriology: ~40–45%
- Mycology: ~10–15%
- Parasitology: ~10–15%
- Virology: ~10–15%
- Laboratory Operations (QA/QC, safety, regulations, method validation, statistics): ~15–20%
Why this mix: specialists are often the go-to for bacteriology and operations questions, while still competent across mycology, parasitology, and virology.
Build Your Mastery: A 12-Week Plan
This plan assumes you already work in micro. If you’re newer, add time to foundational reading and bench shadowing across sections you don’t rotate through.
- Weeks 1–2: Map the territory
- Print the exam content outline and convert it into a one-page checklist.
- Build two master tools: a bench reference notebook (organism ID tables, flowcharts) and an error log (every missed question, with the corrected reasoning).
- Light daily questions (20–30) to sample all domains.
- Weeks 3–6: Deep bacteriology + AST
- Master Gram-positive cocci, Gram-negative rods, fastidious GNs, anaerobes, and mycobacteria.
- Drill biochemical algorithms and resistance mechanisms tied to CLSI breakpoints and test selection.
- Do 30–40 targeted questions/day; write one-page organism profiles (morphology, key tests, pitfalls, AST notes).
- Weeks 7–8: Mycology, parasitology, virology
- Focus on specimen handling, safety, hallmark ID features, and test interpretation (NAAT vs antigen vs serology).
- Practice case stems that hinge on the right test, not trivia.
- Week 9: Laboratory operations
- QC charts, Westgard rules, method validation, CLIA/CAP essentials, biosafety, proficiency testing, LIS/reporting.
- Week 10: Mixed cases
- Do 300–400 mixed questions this week. Every miss goes into the error log with a rewritten stem in your own words.
- Week 11: Simulated exams
- Two full-length practice tests (timed). Post-test: sort errors into knowledge vs. reasoning vs. careless.
- Week 12: High-yield polish
- Review your one-pagers, resistance pearls, tricky organisms, and operations notes. Light questions to keep rhythm.
Fast track (6 weeks): halve the time per block, but keep the structure. Non-negotiables: AST and operations.
Microbiology Core Frameworks You Must Own
Gram-positive cocci (why: high-volume pathogens with critical therapy implications)
- Staphylococcus aureus: coagulase positive; MRSA = mecA/PBP2a; screen with cefoxitin; confirm with PBP2a. D-test for inducible clindamycin resistance.
- Coagulase-negative staph (CoNS): contaminants vs. pathogens—clinical correlation and multiple positive blood culture sets matter.
- Streptococcus pyogenes (Group A): PYR positive, bacitracin susceptible; never report beta-lactam resistance in GAS.
- Streptococcus agalactiae (Group B): CAMP positive; perinatal screening; reverse CAMP helps ID Clostridium perfringens, not GBS.
- Streptococcus pneumoniae: alpha-hemolytic, bile soluble, optochin susceptible; beware false resistance if CO2 incubated with disks not specified for CO2.
- Enterococcus: PYR positive, bile esculin positive, growth in 6.5% NaCl; VRE = vanA/vanB; report high-level aminoglycoside resistance if present.
Enterobacterales and other gram-negative rods (why: ID shortcuts reduce time-to-answer)
- E. coli: indole positive, motile, lactose fermenter; O157:H7 is sorbitol negative on SMAC; confirm with Shiga toxin testing.
- Klebsiella pneumoniae: nonmotile, lactose+, urease variable; K. oxytoca is indole+; think ESBL/AmpC risks.
- Proteus mirabilis vs P. vulgaris: swarming, urease+; mirabilis indole−/H2S+, vulgaris indole+/H2S+.
- Salmonella: H2S+, lysine decarboxylase+; confirm serogrouping; differentiate from Citrobacter freundii (often LDC−).
- Shigella: nonmotile, non-lactose fermenter, H2S−; often few biochemical reactions—confirm with serogrouping.
- Pseudomonas aeruginosa: oxidase+, non-fermenter, growth at 42°C, grape-like odor, green pigment; intrinsic resistance profile.
- Stenotrophomonas maltophilia: oxidase−, non-fermenter, often TMP-SMX susceptible while resistant to many others.
- Acinetobacter: oxidase− coccobacilli; high MDR risk; note colistin-only susceptibility scenarios.
Fastidious gram-negatives (why: test selection and growth needs determine diagnosis)
- Haemophilus influenzae: requires X (hemin) and V (NAD); satellitism around Staph aureus.
- Neisseria: oxidase+, growth on Thayer-Martin; N. gonorrhoeae uses glucose only; N. meningitidis glucose+maltose.
- Moraxella catarrhalis: DNase+, butyrate esterase+; beta-lactamase production common.
- Campylobacter jejuni: curved GNR, microaerophilic, 42°C growth, hippurate+ (jejuni vs. coli).
- Vibrio: oxidase+; on TCBS, V. cholerae = yellow (sucrose+); V. parahaemolyticus = green, halophilic.
- Yersinia enterocolitica: urease+, cold enrichment; CIN agar bull’s-eye colonies; motility at 25°C not 37°C.
Anaerobes (why: specimen selection and presumptive ID guide therapy)
- Bacteroides fragilis group: growth in 20% bile, esculin hydrolysis; often beta-lactamase producers.
- Clostridium perfringens: double zone hemolysis; reverse CAMP positive.
- Prevotella/Porphyromonas: brick-red fluorescence under UV.
- Use kanamycin/vancomycin/colistin disks for presumptive grouping; interpret carefully.
Mycobacteria (why: biosafety and methods are tested)
- AFB stains: Ziehl–Neelsen, Kinyoun; fluorochrome (auramine) is more sensitive.
- Decontamination: NALC-NaOH; culture on solid and MGIT broth.
- M. tuberculosis complex: niacin+, nitrate+ (classic), slow grower; NAAT supports rapid diagnosis.
- NTM highlights: M. avium complex (slow); M. fortuitum/chelonae/abscessus (rapid growers) with distinct drug patterns.
- BSL-3 practices for culture manipulations; always in a certified biosafety cabinet.
Mycology (why: quick visual cues = fast points)
- Yeasts: Candida albicans germ tube+; C. glabrata germ tube−, often dose-dependent azole susceptibility.
- Cryptococcus neoformans: encapsulated; urease+; CSF antigen testing is preferred over India ink.
- Dermatophytes: Microsporum (spindle macroconidia), Trichophyton (pencil-shaped), urease/hair perforation tests assist.
- Dimorphs: Histoplasma, Blastomyces, Coccidioides; mold at 25°C, yeast/tissue form at 37°C; minimize aerosolization.
- Direct exams: KOH, calcofluor white; culture ID can leverage MALDI-TOF or DNA probes.
Parasitology (why: test selection and recognition trump rote memorization)
- Ova & parasite: concentration, wet mounts, trichrome stains; modified acid-fast for coccidia (Cryptosporidium, Cyclospora, Cystoisospora).
- Giardia: pear-shaped trophs; antigen tests common.
- Entamoeba histolytica vs E. dispar: antigen/NAAT needed; trophs with ingested RBCs suggest E. histolytica.
- Malaria: thick (screen) and thin (speciate) smears; P. falciparum rings multiple per RBC, banana gametocytes; P. vivax enlarged RBCs with Schüffner’s dots; P. malariae band forms.
- Helminths: eggs—Ascaris (mammillated), Taenia (striated shell), Schistosoma (terminal or lateral spines).
Virology (why: knowing when NAAT beats culture is key)
- Respiratory: NAAT is most sensitive for influenza/RSV; antigen tests trade speed for sensitivity.
- Herpesviruses: HSV/CMV PCR from appropriate specimens; CMV pp65 antigenemia in certain contexts.
- HIV: 4th-gen Ag/Ab screen, differentiation immunoassay, then RNA if needed.
- Hepatitis B markers: HBsAg (infection), anti-HBc IgM (acute), anti-HBs (immunity), HBeAg (replication).
Antimicrobial susceptibility testing (AST) and resistance (why: core specialist skill)
- Methods: Kirby–Bauer disk diffusion, broth microdilution, MIC, E-test; follow CLSI breakpoints.
- D-test: inducible clindamycin resistance in staph/strep.
- ESBL and AmpC: altered cephalosporin patterns; avoid 3rd-gen cephalosporins for serious ESBL infections despite in vitro “S.”
- Carbapenemases: KPC, NDM, OXA-48-like; phenotypic screens (e.g., Carba NP) or molecular assays.
- Stewardship: report cascade, suppress uninterpretable drugs, add comments that guide therapy.
Molecular and rapid ID (why: time-to-result impacts care)
- MALDI-TOF for rapid ID from colonies; be aware of limitations (e.g., closely related species).
- Rapid panels (blood culture, respiratory, GI): interpret in clinical context; contamination vs. true pathogen matters.
- NAAT algorithms: C. difficile toxin EIAs vs NAAT reflex, MRSA/MSSA screening, TB NAAT on AFB-smear positives.
Case Patterns the Board Loves
- “UTI” with 30,000 CFU/mL mixed flora: Likely contamination. Why: mixed growth and low colony count from non-sterile collection. Action: request recollection, unless catheter/suprapubic specimen or strong symptoms suggest significance.
- Positive blood culture with CoNS in 1 of 4 bottles: Probable contaminant. Why: single bottle, skin commensal, no intravascular device. But if 2+ sets grow the same CoNS in a patient with a central line and fever, treat as pathogen.
- Beta-hemolytic colonies, catalase−, bacitracin susceptible: S. pyogenes. Why: classic phenotype; report without AST (uniform penicillin susceptibility).
- Inducible clindamycin resistance scenario: Erythromycin R, clindamycin S on screen; perform D-test. Flattened D zone = report clindamycin R. Why: prevents clinical failure.
- Watery diarrhea, NAAT positive for C. difficile, toxin EIA negative: Likely colonization or low-toxin disease. Why: NAAT detects genes; toxin reflects active toxin production. Follow your lab’s algorithm and report interpretive comment.
- AFB smear positive, NAAT positive for MTB complex: TB likely. Why: combined smear and NAAT increases PPV; initiate isolation/reporting per policy.
Quality, Safety, and Regulations in Practice
- Pre-analytical: Reject poor sputum (Bartlett score), ensure adequate blood culture volume (most critical factor for yield), and proper transport (e.g., stool for O&P without fixative? reject or route appropriately).
- QC and statistics: Levey–Jennings charts; recognize shift vs trend; apply Westgard rules (e.g., 1-3s, 2-2s) to decide when to stop and troubleshoot.
- Method validation: accuracy, precision, reportable range, LoD/LoQ, reference intervals (where applicable); correlation studies when bringing on new methods.
- Regulatory: CLIA complexity, CAP checklist items, proficiency testing handled exactly like patient specimens, documented competency.
- Safety: BSL-2 for routine micro; BSL-3 practices for AFB cultures and certain dimorphs; always use a certified biosafety cabinet for aerosols. Spill management and exposure follow-up are testable steps.
- Reporting: Critical values (e.g., positive blood culture, CSF pathogens) require immediate call and read-back; public health reporting for TB, Salmonella, etc., per jurisdiction.
How to Study Day-to-Day
- Active recall over passive reading: Close the book and draw the Staph/Strep/Enterococcus decision tree from memory. Fill what you miss. Repeat daily.
- One-pagers: For each organism group, include colony/G stain, 3–5 decisive tests, typical sources, and AST pitfalls. Why: compresses memory and speeds review.
- Error log: For every missed question, note the wrong reasoning and write the correct trigger. Example: “S. saprophyticus—young woman UTI, novobiocin resistant.” Review this log twice weekly.
- Bench simulation: Explain aloud why you’d reject a specimen, escalate a result, or add a test. This mirrors the exam’s scenario logic.
- Question cadence: 30–50/day on weekdays; 100–150 on weekends. Stop guessing—look up each uncertain point and add to your notebook.
- spaced repetition: Cycle high-yield cards (MRSA mecA/PBP2a, ESBL rules, H. influenzae X/V needs, malaria species) at increasing intervals.
Exam-Day Game Plan
- Time management: First pass = answer what you know and flag the rest. Aim to clear the test with 20–30 minutes left for flagged items.
- Discipline your reading: Underline in your head the specimen type, patient context, and method. Many stems hinge on one of these.
- Eliminate aggressively: If two answers contradict a core fact (e.g., “N. meningitidis ferments only glucose”), cross them out immediately.
- Don’t fight the bench: If your lived experience and the question’s data align, trust it. The exam is written by people who run labs.
- Close strong: Revisit flags, but only change an answer for a concrete reason (missed keyword, misread value), not anxiety.
Quick High-Yield Reminders
- Optochin S/bile soluble = S. pneumoniae.
- PYR+ and bile esculin+ and 6.5% NaCl growth = Enterococcus.
- Novobiocin R UTI in a young female = S. saprophyticus.
- Germ tube+ yeast = Candida albicans.
- Yellow on TCBS = Vibrio cholerae (sucrose+).
- D-test positive = report clindamycin resistant.
- AFB smear+ and NAAT+ = treat/report for TB pending culture.
- Blood culture volume > number of sets for yield.
If You’re New vs. Experienced
- Newer to micro: Spend your first two weeks just on specimen types, media, atmospheric requirements, plate reading, and basic biochemical logic. Why: without these, organism facts won’t stick.
- Experienced bench scientist: Push hard on AST nuance, regulatory/validation, and organisms you rarely see (dimorphs, coccidia, fastidious GNs). Why: these are the points you’re likeliest to miss.
Final Thoughts
Passing SM(ASCP) isn’t about memorizing every organism—it’s about thinking like the person everyone else calls when they’re stuck. Build a small set of reliable frameworks, drill the “why” behind every test and report, and practice case reasoning until it feels like another day on the bench. Do that, and the exam becomes a structured version of what you already do well.